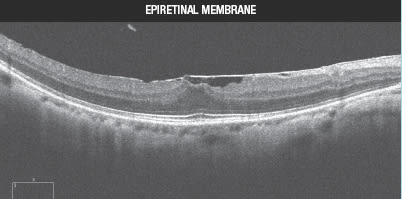

Removing Ambiguity From Your Retina Examination
Imaging with the Cirrus HD-OCT aids differential diagnosis of macular holes.

By Brandon J. Lujan, MD
When is a macular hole not a macular hole? Before the introduction of OCT, the answer to this question was not always readily apparent by clinical examination alone, except by the masters of the contact lens examination. With the emergence of spectral domain OCT (SD-OCT), the playing field has been leveled, and all ophthalmologists are able to appreciate the subtleties of vitreoretinal interface disorders. Indeed, the terminology and how we think about full-thickness macular holes, lamellar holes and epiretinal membranes, has changed. The following cases illustrate how symptomatology and clinical examination can initially be ambiguous among the spectrum of these disorders. However, the Cirrus HD-OCT findings can be used to confirm different diagnoses, which may lead to a distinctly different management course.
Accurate Diagnosis is Crucial
Vitreoretinal interface pathology identification and classification are frequent topics for discussion among retina specialists. As these cases illustrate, initial clinical impressions can be ambiguous. However, Cirrus HD-OCT can be an invaluable aid in making an accurate diagnosis, which is critical to ensure timely interventions or appropriate referrals. ■
| Case 1 |
|---|
A 61-year-old woman is evaluated for gradually decreasing vision in her right eye for the past several months. Her visual acuity is 20/100, and she has central distortion and scotoma on Amsler grid testing. On clinical examination, there appears to be a macular hole with a cuff of retinal fluid. Imaging with the Cirrus SD-OCT in 5-line raster mode (Figure 1) shows a full-thickness break in the retina, with continuity between the vitreous and the RPE. There is cystic-appearing intraretinal fluid, and the retina has a typical rolled edge appearance. Although material within the retinal hole appears slightly more reflective than the vitreous, the bright reflectivity of the retinal pigment epithelium (RPE) and underlying choroidal structures confirms the absence of intact retinal tissue anteriorly. This patient does, indeed, have a full-thickness macular hole. She underwent pars plana vitrectomy with intravitreal gas and face-down positioning.
|
| Case 2 |
|---|
| A 60-year-old man is evaluated for decreased vision in his left eye for several months. His visual acuity is 20/60, and he has distortion on Amsler grid testing. On clinical examination, this patient appears to have a macular hole. Imaging with the Cirrus SD-OCT in high-definition 5-line raster mode (Figure 2) reveals a thickened irregular ERM on the temporal (right) side of the scan. A defect in the inner retina becomes continuous, with a splitting between the retinal layers. This is not a full thickness defect, however, and outer retinal tissue remains intact. The diagnosis in this case is a lamellar hole. We do not have good longitudinal data on lamellar holes, but our clinical experience is that they can remain stable or they can slowly enlarge over time, and it is currently unclear which signs are suggestive of progression and further vision loss in a specific patient. The general consensus in the retina community is that surgery offers no benefit, and this patient was observed. 
|
| Case 3 |
|---|
A 58-year-old man is evaluated for decreased vision in his left eye for several months. His visual acuity is 20/40, and he has distortion on Amsler grid testing. On clinical examination, this patient appears to have a macular hole. Imaging with the Cirrus SD-OCT in high-definition 5-line raster mode (Figure 3) shows a highly reflective membrane on the surface of the temporal (right) retina with a distortion of the inner retinal foveal contour. There is no loss of retinal tissue, thus excluding a diagnosis of full-thickness macular hole. Furthermore, there is no splitting of retinal layers in this image nor in other slices from the macular cube, thus excluding a diagnosis of lamellar hole. There is a mild amount of retinal thickening, however, and this patient has an epiretinal membrane. Because the patient's vision and distortion were not intolerable, the decision was made to observe with close follow-up. If the condition worsens, vitrectomy could be performed.
|
Brandon J. Lujan, MD, is a medical retina and imaging specialist with West Coast Retina in San Francisco. He can be reached at eyeojo@gmail.com.








